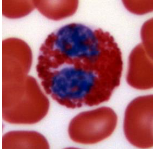
term image

1/6
Looks like no tags are added yet.
Name | Mastery | Learn | Test | Matching | Spaced | Call with Kai |
|---|
No analytics yet
Send a link to your students to track their progress

segmented neutrophil
phagocytic, important for fighting bacterial infection

band neutrophil
immature neutrophil

lymphocyte
mature in bone marrow (b-cells) and secrete antibodies or they marture in the thymus (T-cells) and are involved in adaptive cellular immune responses. Their levels are high in people fighting viral infections.

atypical lymphocyte

monocyte
These find and destroy germs (viruses, bacteria, fungi and protozoa) and eliminate infected cells. Monocytes also call on other white blood cells to help treat injury and prevent infection.
eosinophil
These fight parasitic infections.

basophil
These fight allergens, pathogens and parasites. Basophils release histamine to improve blood flow to damaged tissue and heparin to prevent unwanted blood clots. Abnormal basophil levels may rise because of allergic reactions or cancer.